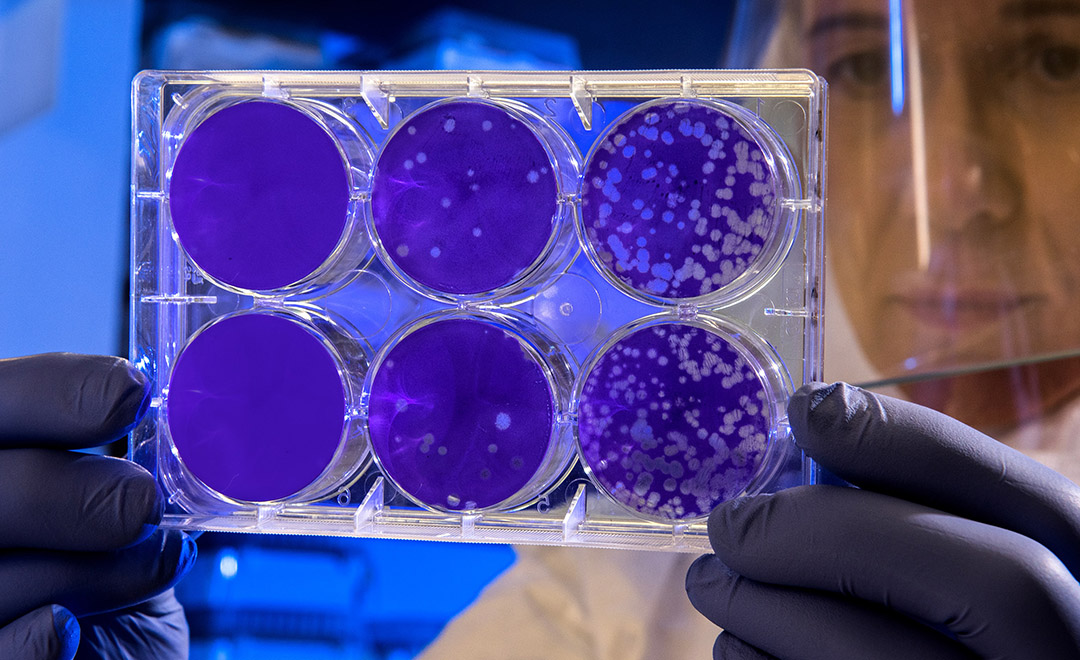

The Hebrew University’s (inter-departmental) equipment unit in Ein Kerem has teamed up with the national effort to test for coronavirus. With the help of the staff and two complex robots, the unit will begin analysing the samples at a rate of 1,000 tests per day. Following a callout, dozens of graduate students (graduates from the Faculty of Medicine) who have experience in lab work expressed their willingness to volunteer and the Faculty interviewed them and trained them to help with the national effort.